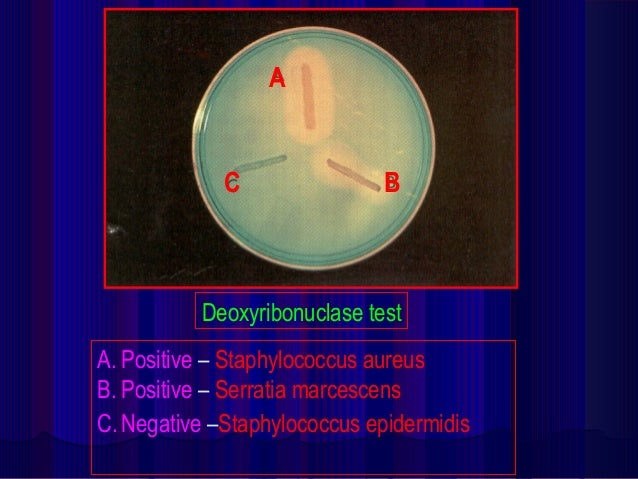
of composition urea tests (1st Biochemical part) of composition urea tests (1st Biochemical part)

77 COMPOSITION OF UREA
COMPOSITION OF UREA
Hai, many thanks for visiting this web to find composition of urea. I really hope the article that appears may be helpful to you









Characteristics of Waste Water (Unit I) , GRANULAR UREA Yara UK , Biological Fertiliser Human Urine The Permaculture Research Institute , Solutions , Engineers Guide: The Snamprogetti Urea Process Description , Cerebrospinal Fluid , Cerebro Spinal Fluid CSF , Biochemical tests (1st part) , Fumigation of ot , Structure of Cell Youtube Lecture Handout Translation in Hindi, Kannada, Malayalam, Marathi , Walnut Shell Blasting Composition Materials Co. , Arsenic Trioxide,Arsenic Trioxide Powder,Arsenic Trioxide Chemical Manufacturers in India , Blood vs Plasma Difference and Comparison Diffen , Isdin Ureadin Ultra 40 Gel Oil 30ml ,
Hai, many thanks for visiting this web to find composition of urea. I really hope the article that appears may be helpful to you

Belum ada Komentar untuk "77 COMPOSITION OF UREA"
Posting Komentar